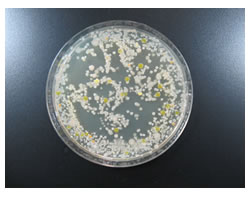
まな板の除菌 プロが教える除菌のポイント コツ キッチンアルペット サラヤ株式会社 家庭用製品情報

"まな板"に付いている菌の種類 まな板に付いている菌の多くは主に大腸菌です。また食中毒や感染症の原因となる黄色ブドウ球菌、緑膿菌も付いています。 カビも繁殖しています。 高温多湿な環境では、まな板にわずかに菌や汚れが残っていると菌が菌が体に入ってからそれぐらいの時間で症状がでるのですか? a4 菌を摂取してから発症までの期間(潜伏期間)が、2日から7日(平均2日から3日)と他の食中毒菌に比較して長いのが特徴です。 q5 症状がでたときはどのように対処すればよいのですか? a5まな板は,新品の抗菌プラスチック製まな板(抗 菌スーパー耐熱まな板,270×500×mm,ポリエ チレン製,住ベテクノプラスチック株式会社)を4 枚用いた。汚染度を測定するための試験区画は,ま な板の中央に100×150mm の目印をつけて定めた (図1)。

ダイソー 100均 の除菌スプレー 容量や有効な菌の種類など 100均グッズや格安商品を愛でるブログ
まな板 菌 種類
まな板 菌 種類-殺 菌 各調理にて使用。 まな板、包丁に関しては、用途(生用 / 加熱品用 / 野菜用 等)に分け て使用。 まな板 ①使用後、殺菌済みのたわし・スポンジを用いて、洗剤でしっ かりと洗浄する。 ②殺菌済みのふきんでまな板を拭き上げ、まな板上の水分を肉の種類 主な病原体 牛肉、 牛レバー ( 生食禁止 ) 腸管出血性大腸菌o157、 カンピロバクター等 豚肉・豚レバー等の内臓 ( 生食禁止 ) e型肝炎ウイルス、 有鉤条虫(寄生虫)等 鶏肉、鶏レバー



東海コープ 商品検査センター お届けする商品の品質を科学の目で確かめる
第1章 食器の洗浄・消毒マニュアル 1 1 「食器の洗浄・消毒」の基本的な考え方 〈洗浄について〉 *洗浄は、食器に付着したたんぱく質やでんぷんなどの有機物による汚れを落とすことである。 まな板の種類 まな板は使われる素材によって特徴が異なります。 自分に合ったまな板選ぶには各素材ごとのメリットとデメリットを把握することが大切です。 ・プラスチック 1,000円以下で買えるリーズナブルな値段のため、現在主流となっているまな板特に、肉・魚・野菜など、 利用食材ごとにまな板の使い分けをしていない店は要注意 です。 生肉を切ったまな板には、肉の表面についている菌が付着しています。その菌をしっかりと洗浄・除菌・漂白しないまま、同じまな板で刺身を切った場合どうなるでしょうか?
ろん新らしいまな板と古いものでは効果がちがってくる。 実験成績の一例を第!表 に示してみよう。 第1表 まな板用殺菌灯の効果 注)供 試菌,大腸菌(Eco1i,1)ブ ドウ球菌(Staphaureus 9P),15W型 殺菌灯2灯使用,照射距離1m・乱反射板使用まな板には抗菌・抗カビ効果が期待できるヒノキを使用。サイズや形状の種類も豊富なので、木製のまな板を探している方はぜひチェックしてみてください。 まな板のおすすめ|木製 エピキュリアン(Epicurean) カッティングボード Mまな板 抗菌まな板 家庭用まな板 業務用まな板 フライパン 浅いフライパン 深いフライパン 卵焼き用 こだわりの鉄フライパン ナベ 圧力鍋 浅いナベ 深いナベ ケトル・やかん
食材ごとについている細菌の種類が違うのでまな板や包丁を使い分けることも大切です。 生肉やお魚には、食中毒の原因になる菌が多い んです。 お肉や魚は加熱して食べるので問題ありませんが、生で食べる野菜などを一緒に扱うのは危険です。まな板のお手入れはとにかく菌を残さないことです。 抗菌加工されたまな板でも漂白剤などを使ってしっかりと殺菌してください。 また濡れたまな板に菌が残っているとまたたく間に菌が増殖してしまうので、完全に乾燥させることも必要です。 食洗機 梅雨の季節、 高温多湿の状態が続くと心配になってくるのが食中毒などの細菌です。 料理をする時に使うものと言ったらまな板ですが、 ちゃんと対策をしておかないと食中毒になってしまうかもしれません。 そこで今回はまな板の殺菌のやり方と、材質による違い、日々の洗い方につい




花王 住まいの菌実態大規模調査 キッチン ダイニングは トイレ床と同等レベル以上の菌数 冷蔵庫野菜室は 要注意スポット 花王株式会社 花王mkニュース のプレスリリース




雑菌だらけのまな板を常に清潔に保つ方法は プラ製と木製の注意点 お洗濯 お掃除の教科書
抗菌まな板 新素材「特殊エラストマー」を採用。 特殊な抗菌剤を練り込んでおり、半永久的な抗菌力で大腸菌などの増殖を抑えます。 木製のようにソフトな刃当たりで、包丁にも手にも負担がかかりません。 表面はゴム製のように弾力性があり、雑菌 まな板の表面の小さな傷などに入り込んでいるのかもしれません。 まな板の菌、なかなか手ごわいです。 今度は、細菌の除菌効果が高いfabミストをまな板にスプレーして30分待ってから これまでと同じように培地を押し当ててみました。サルモネラ属 Salmonellaの細菌は数種類の感染症を引き起こします。最もよくみられるものは胃腸炎 胃腸炎の概要 胃腸炎とは、胃、小腸、大腸の粘膜に生じた炎症のことです。 通常は微生物が感染することで起こりますが、毒性のある化学物質や薬の摂取が原因で起こることもあります。




きれいのミカタ 丸めて煮沸消毒できるまな板 プラチナシリコン Silteq 全5色 電子レンジ除菌の通販はau Pay マーケット クッキングクロッカ




まな板キレイ乾燥機 システムキッチン 住まいの設備と建材 Panasonic
木製まな板は刃のあたりが良く、食材もカットしやすいのが特徴。 木の種類(ひのき、ひばな等)によって刃のあたり具合は若干異なりますが、 基本的には包丁の刃が傷みにくいことも大きな特徴といえます 。 木製まな板のデメリットとしては、 プラスチック製よりも重くて高額になりがち食中毒をおこす細菌やウイルスの種類が違っても、食中毒を予防するための共通のポイントがあります まずは予防のポイントを知っておきましょう。 生の卵・肉・魚介類にさわったら、よく手を洗いましょう。 包丁やまな板を使うときは、生野菜などの 細菌の種類によって増殖に適した温度は違いますが、食中毒菌の多くは30~37度の間で増殖が活発に進みます。 水分 増殖には水分が不可欠です。室内の湿度が低くても、まな板や包丁などが濡れていれば、増殖します。 栄養分




実は手軽 スポンジ まな板の簡単除菌方法 コラム サツドラ サッポロドラッグストアー




乾燥したままの使用ng まな板の 正しい使い分け と 清潔に保つコツ 東京ガス ウチコト
まな板の傷にひそむ菌!その種類や数、繁殖スピードは? 食中毒の感染経路などにもなる「まな板」 包丁で切る度に傷が付きその傷の中に 菌が留まり繁殖するといいます。 まず、その数ですがとある調査結果では、A1 包丁・まな板は、確実に洗浄し、水気を切ってから保管します。 細菌を99.9%殺すのに必要な殺菌線量は細菌の種類によって異なります。大腸菌を 使用目的 種類と主成分 対象物の例 特徴・注まな板 10² 10³ 10₄ 10₅ 食器洗いには除菌タイプの洗剤を使うなど、手拭きタオルに対する汚れの意識はないようでした。拭取り 検査では、ほとんどの場所で多くの菌が検出され、大腸菌群も検出されました。さらに、酵母や、カビも検出さ




セレクト100 キッチンナイフ3本 キッチンツールセット 貝印 Select100 三徳 ペティ フルーツナイフ ブレッドナイフ まな板 ピーラー シャープナー Kai 快適家電デジタルライフ Butlerchimneys Com




Amazon 京セラ まな板 約30 Cm 抗菌 柔らかい 薄い 軽い 目盛り 付き 漂白 除菌 Ok ブラック 日本製 Kyocera 99 包丁セット オンライン通販
そんなまな板の上で食材を切るのは、かえって危険ですよね。 漂白剤の原液使用はできるだけ避け、薄めたものを使うようにしましょう。 プラスチック製と木製はどちらがいい? まな板の種類で分かれるのは、主にプラスチック製と木製だと思います。1 販売価格 (税別) ¥74,900~ 税込¥,390~ (14種類の商品があります) EBM 電気式 紫外線 庖丁殺菌庫 キチンエース 1個 特長庖丁・まな板・フキン・小物調理器具などを殺菌し、同時に保管する便利で衛生的な殺菌庫です。 庫内に取り付けてある殺菌




まな板を衛生的に使い分ける方法と清潔に保つための工夫 シュフーズ




暮らし まな板は菌の温床 菌を防ぐ使い方 と 漂白 で清潔を目指そう 家電 Watch




楽天市場 きれいのミカタ 丸めて煮沸消毒できるまな板 Mサイズ プラチナシリコン Silteq 全5色 電子レンジ除菌 食洗機対応 耐熱 カッティングボード シルテック 白 黒 送料無料 あす楽 クッキングクロッカ 楽天市場店




21年 家庭用のおすすめまな板12選と選び方を紹介 価格 Comマガジン




心配な食中毒 あなたはどのようにして防いでいる 百聞を一軒に活かす 百一




まな板の熱湯消毒 比べる 調べる エフシージー総合研究所




送料無料 ハセガワ 抗菌ラバーラかるがる まな板 Srb25 7535 750 350 25mm 送料無料 新規購入 Www Fundasamin Org Ar

まな板の除菌 プロが教える除菌のポイント コツ キッチンアルペット サラヤ株式会社 家庭用製品情報




まな板の素材別除菌方法と 毎日の 簡単3ステップ お手入れ方法




除菌 消臭 次亜塩素酸 除菌スプレー 無害 安心 安全 清潔 ペット 消臭スプレー まな板除菌 食中毒 ウイルス 菌 赤ちゃん 高濃度 Arbol 新しい生活様式 アルボル 手指消毒剤 塩素 亜 花粉 ベビー ファクトリーアウトレット 酸 除菌消臭 次 次亜塩素酸詰め替え用 1800ml 1




清潔を保つ まな板の除菌 お手入れ方法 長谷工グループ ブランシエラクラブ



東海コープ 商品検査センター お届けする商品の品質を科学の目で確かめる




除菌 プラス 製品特長 食器用洗剤 Magica マジカ ライオン株式会社




徹底比較 まな板のおすすめ人気ランキング21選 おしゃれで衛生的 Mybest




まな板の種類とオススメのお手入れ方法 高橋練染株式会社



1




プラスチック派 木製派 まな板 の選び方を衛生のプロが伝授 Macaroni




公式 ショップディズニー ミッキー 除菌 消臭スプレー 清潔 快適



Born Made まな板 除菌器 Tpu素材 抗菌まな板3枚付き おしゃれ K01 001 Highmountセカンド 通販 Yahoo ショッピング



1




花王株式会社 ハイター 知ってる 菌のこと




衛生管理も使い勝手も文句なし 電子レンジで除菌もできる便利な調理道具 Ippin イッピン




p g 除菌ジョイコンパクト 緑茶の香り つめかえ用 ジャンボ 1330ml ホームセンター通販 カインズ




きれいのミカタ 丸めて煮沸消毒できるまな板 プラチナシリコン Silteq 全5色 電子レンジ除菌の通販はau Pay マーケット クッキングクロッカ




魚をさばくプロに聞いた クーラーボックスと一緒に除菌せよ 魚調理後のまな板の除菌方法 ジギング魂




ありそうでなかった Uv Cライトと乾燥機能でまな板や包丁を除菌するサンコーの専用まな板付き除菌収納スタンド Dime アットダイム




食中毒の原因って キレイキレイ ライオン



アルコール除菌 キッチン ラボ 研究レポート 梅雨 夏のまな板は要注意 軽く洗ったまな板の雑菌は12時間後に50 000倍に増殖 アルコール除菌 キッチン ラボのプレスリリース




送料無料 まな板除菌器 Tpuまな板 3枚セット Born Made 配送業者の指定 日時指定は承っておりません Japanec Town Life




知る ことで食中毒から身を守る 第2回 家庭で発生しやすい食中毒菌と殺菌方法 ニチレイ こおらす



二次汚染に注意 食中毒の予防 オーヤラックス




知る ことで食中毒から身を守る 第2回 家庭で発生しやすい食中毒菌と殺菌方法 ニチレイ こおらす




アルコール除菌スプレー エタノール 57 250ml 個 合計5l 福岡県嘉麻市 ふるさと納税 ふるさとチョイス




まな板を除菌できるキッチン 住宅リフォームのpanasonicリフォームclub




検証 まな板の鉄板おすすめ人気ランキング10選 ニトリのまな板シートを実際に購入して使ってみました




徹底比較 まな板のおすすめ人気ランキング21選 おしゃれで衛生的 Mybest




再再販 まとめ買い10セット 濃縮スマートギフト ライオントップナノックス 10g 3 P G除菌ジョイ 洗剤セット プレゼント ギフト 贈り物 結婚祝い お祝い 洗濯用洗剤 ナイススタイル 最安値に挑戦 Montepio Imq Es




そろそろ買い替え時かも 長く使える まな板 の選び方とお手入れ方法 キナリノ




まな板の漂白方法 漂白剤の種類や注意点をご紹介 くらしのマーケットマガジン



東海コープ 商品検査センター お届けする商品の品質を科学の目で確かめる




まな板を除菌できるキッチン 住宅リフォームのpanasonicリフォームclub




花王株式会社 ハイター 知ってる 菌のこと




台所のまな板 意外と汚いです ノd 株式会社ビッグバイオ



まな板のおすすめ商品4選 正しい洗い方除菌方法も Life Net




微生物検査とatpふき取り検査 A3法 の違いについて Atpふき取り検査 A3法 キッコーマンバイオケミファ




乾燥したままの使用ng まな板の 正しい使い分け と 清潔に保つコツ 東京ガス ウチコト




台所番長がお薦め 除菌 抗菌に優れたまな板3選 Nikkei Style



東海コープ 商品検査センター お届けする商品の品質を科学の目で確かめる



Born Made まな板 除菌器 Tpu素材 抗菌まな板3枚付き おしゃれ K01 001 Highmountセカンド 通販 Yahoo ショッピング




比べる 調べる 96 まな板の細菌 熱湯消毒が有効 1 3ページ 産経ニュース



Born Made まな板 除菌器 Tpu素材 抗菌まな板3枚付き おしゃれ K01 001 Highmountセカンド 通販 Yahoo ショッピング




まな板 スポンジを除菌 漂白 トイレの万倍の細菌から救え Yourmystar Style By ユアマイスター




包丁の除菌方法とは 熱湯除菌やアルコール除菌がおすすめ 家事 オリーブオイルをひとまわし




菌への正しい対策で食中毒を防ごう 健康のドクターズアドバイス 伊藤園の公式通販 健康体




まな板の除菌 プロが教える除菌のポイント コツ キッチンアルペット サラヤ株式会社 家庭用製品情報




ダイソー 100均 の除菌スプレー 容量や有効な菌の種類など 100均グッズや格安商品を愛でるブログ




まな板 を清潔に保つための5つのポイント




食中毒予防の原則と6つのポイント 暮らしに役立つ情報 政府広報オンライン




豚肉や豚の内臓 レバーなど による食中毒などにご注意ください 食品安全委員会 食の安全 を科学する




アルコール 除菌スプレー 国産 エタノール ふるさと納税 エタノール57 配合のキッチン用除菌剤です まな板や包丁などの除菌 やドアノブやテーブルの上の除菌にもご使用いただけます 57 福岡県 携帯用 除菌剤 30個 日本製 60ml 30個 持ち歩き 持ち運び スプレー




食品衛生関連および微生物 食品工場に特化したコンサルティング 木本技術士事務所




梅雨時期の 作りおき はリスク大 知っておきたい 食中毒 対策の盲点とは 代 40代の主婦1 000名に調査




まな板 ふきん 排水口 キッチンに潜む菌を撃退 除菌 消臭大作戦 応援 くらしのキレイ 花王 くらしの研究




おすすめまな板の素材別人気ランキング10選 選び方も解説 Limia リミア




楽天市場 高濃度2 000ppm 除菌314 350ml ウイルス対策に 314種類の菌やウイルスを除菌する 除菌 抗菌 消臭 無香料 Phmb配合 肌荒れしない除菌スプレー 10p03dec16 宮崎産直 楽天市場店




清潔を保つ まな板の除菌 お手入れ方法 長谷工グループ ブランシエラクラブ



伴野内科クリニック




まな板はここまで進化した 今 選ぶべき おすすめ選 By 業務用厨房 備品を探そう 飲食店 Com




ベテラン主婦推薦 本当におすすめのまな板はコレ 選び方 お手入れ方法まで徹底解説 ベルメゾン 暮らしのコラム




ベテラン主婦推薦 本当におすすめのまな板はコレ 選び方 お手入れ方法まで徹底解説 ベルメゾン 暮らしのコラム




家庭でも起こりうる 食中毒 を防ぐ これからの季節は要注意 トピックス Hanako ママ Web




Chopbox 10 機能を兼ね備えた世界初のスマート カッティングボード Campfire キャンプファイヤー



使った後のまな板や台ふきんは雑菌だらけ 衛生微生物研究センターが キッチンの衛生管理 に関する実験結果を発表 衛生微生物研究センターのプレスリリース




各種ウイルス 細菌に優れた効果を実証済みの画期的な除菌用アルコール製剤 弱酸性でお子様にも安心 ジェームズマーティン 除菌用アルコール James Martin ジェームズ マーティン 新品 送料無料 抗カビ フレッシュサニタイザー 除菌 消臭 1000ml 詰替え用 子ども 手洗い




ありそうでなかった Uv Cライトと乾燥機能でまな板や包丁を除菌するサンコーの専用まな板付き除菌収納スタンド Dime アットダイム




まな板の熱湯消毒 比べる 調べる エフシージー総合研究所




Amazon 京セラ まな板 約30 Cm 抗菌 柔らかい 薄い 軽い 目盛り スタンド 付き 漂白 除菌 Ok ピンク 日本製 Kyocera Cc 99 Pk 包丁セット オンライン通販




知らないうちに意外と汚れている まな板を清潔に保つお手入れ方法と管理方法 Goo Goo Foo




まな板の除菌 漂白って毎日するものなの 正しい除菌 漂白の仕方を見てみよう 花王プロフェッショナル 飲食店経営と衛生管理を応援する ご贔屓ナビ




まな板の熱湯消毒 比べる 調べる エフシージー総合研究所



1




比べる 調べる 96 まな板の細菌 熱湯消毒が有効 1 3ページ 産経ニュース




まとめ ミツエイ 食添ブリーチ 本体 1500ml 1本 30セット 北海道 沖縄 離島配送不可 まな板 食器の除菌 漂白から野菜の洗浄まで について 本体洗剤の種類 Boobarcelona Com




まな板 おすすめタイプ別12選 Amazon 楽天で買える Classy クラッシィ




殺菌率99 9 除菌 乾燥 収納がワンタッチで 家庭用包丁 まな板消毒機 Campfire キャンプファイヤー



1




スポンジ まな板 ふきんの除菌ができ 食器は速く乾いて清潔に洗いあがる台所用洗剤 Charmy Magica 速乾 プラス カラッと除菌 新発売 ライオン株式会社のプレスリリース




清潔を保つ まな板の除菌 お手入れ方法 長谷工グループ ブランシエラクラブ




まな板と包丁を紫外線で除菌できる送風乾燥スタンド サンコー マピオンニュース




衛生管理も使い勝手も文句なし 電子レンジで除菌もできる便利な調理道具 Ippin イッピン




木のまな板のお手入れ 長く愛用するためのお手入れ方法 暮らしの工夫 Com




衛生の基礎知識 洗浄 除菌 サニテーション 衛生用品や 衛生関連の情報メディア 衛生スタイル




最新時短家電 ワンタッチで 除菌 乾燥 収納 一台三役のまな板除菌 器が日本国内での販売開始に先駆けて19年9月1日よりgreenfundingにて先行販売開始 株式会社imacleのプレスリリース




まな板に最適な木材ランキング 木の種類によるメリットとデメリット 総合評価 杉本木工々房 杉本木工々房




まな板の漂白方法 漂白剤の種類や注意点をご紹介 くらしのマーケットマガジン




キッチン用品 除菌は大丈夫 台ふきん 生乾きはng Nikkei Style



0 件のコメント:
コメントを投稿